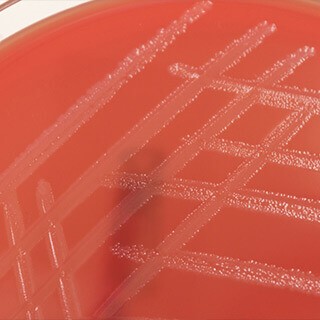

Ductal carcinoma
Ductal carcinoma in situ (DCIS) is the presence of abnormal cells in the lining of the milk ducts. Even though “carcinoma” is included in its name, DCIS is considered a precancerous condition. It is the most common type of non-invasive breast cancer, accounting for about 20 percent of new breast cancer cases.
Ductal carcinoma in situ (DCIS) is the presence of abnormal cells in the lining of the milk ducts. Even though “carcinoma” is included in its name, DCIS is considered a precancerous condition. It is the most common type of non-invasive breast cancer, accounting for about 20 percent of new breast cancer cases.
Because DCIS is still contained within the ducts, it is not life-threatening—so if you’re diagnosed, you have time to research your treatment options. Left untreated, some DCIS can eventually develop into invasive cancer. Because there is no way to tell which DCIS will evolve into invasive cancer and which won’t, it is very important to treat all DCIS.
DCIS Facts:
- Treatment is almost always successful.
- About 60,000 cases diagnosed annually in the US.
- Does not require chemotherapy.
- Increases your risk of developing another breast cancer.
Women with DCIS seldom have symptoms; you usually can’t see or feel it. Some women may notice a discharge from the nipple, but most DCIS is discovered by mammography. If a mammogram discovers questionable microcalcifications in your breast, a needle biopsy will determine whether the cells are benign or malignant.
If a biopsy shows you have DCIS, your treatment will depend upon the size, location and characteristics of the disease, as identified in your pathology report. Most women can be treated with a breast-conserving lumpectomy. This removes the cancerous area and a small margin of surrounding tissue, and is usually followed by radiation to reduce the risk of recurrence. You may have another mammogram to make sure no DCIS cells remain in the breast—when DCIS is completely removed, it can’t regenerate or become invasive.
Although DCIS is usually treated with lumpectomy and radiation, mastectomy is recommended when:
- The margin of tissue around the tumor also contains cancerous cells.
- DCIS is present in more than one quadrant of the breast.
- Removal of the cancerous area will significantly reduce and disfigure the breast.
- You can’t have or prefer not to have radiation.
- You are diagnosed with DCIS and you are at high hereditary risk for breast cancer.
Survival rates are the same for women who have lumpectomy with radiation compared to those who have mastectomy.If you are post-menopausal and your DCIS is found to be estrogen-positive (needs estrogen to grow), your physician may recommend tamoxifen for five years to reduce the risks of recurrence and developing new breast cancers.
Invasive Ductal Carcinoma (IDC)
Invasive Ductal Carcinoma (IDC), also called Infiltrating Ductal Carcinoma, is the most common type of breast cancer. It begins in the milk ducts, spreads into the fatty breast tissue, and can metastasize to other parts of the body.
Unlike symptomless DCIS, women with IDC often feel a lump in their breast. Depending on the size and biology of your IDC, you’ll be treated with a lumpectomy and radiation, or a mastectomy. One of more of your underarm lymph nodes will be removed, to determine whether cancerous cells have entered your blood stream. If IDC cells are found in your nodes, treatment will be more extensive.
IDC Facts:
- Accounts for 85 percent of all breast cancers.
- Grows for 8–10 years before it can be felt or detected by a mammogram.
- Treated with surgery and chemotherapy.
Invasive cancers, including IDC, are treated on two levels. Surgery and radiation eradicate cancer in the breast and prevent it from returning. Chemotherapy given orally or by injection targets cancer cells that have spread beyond the breast.
If you are pre-menopausal, Zoladex or Lupron may also be prescribed. If you are post-menopausal, an aromatase inhibitor, such as Arimidex or Femara will likely be recommended. If your tumor is hormone sensitive, your doctor may recommend tamoxifen to slow or halt your cancer’s growth. If your hormone-positive IDC has not spread to your lymph nodes, the Oncotype DX test (www.genomichealth.com) can help assess your risk for recurrence.
About 25 percent of women with invasive breast cancer have tumors that produce too much of a protein called HER-2. A tumor that is HER-2 positive grows quickly, is more resistant to standard chemotherapy, and is more likely to recur. Herceptin, a drug used to fight metastatic breast cancer, is now given in combination with chemotherapy to treat HER-2 positive tumors.







